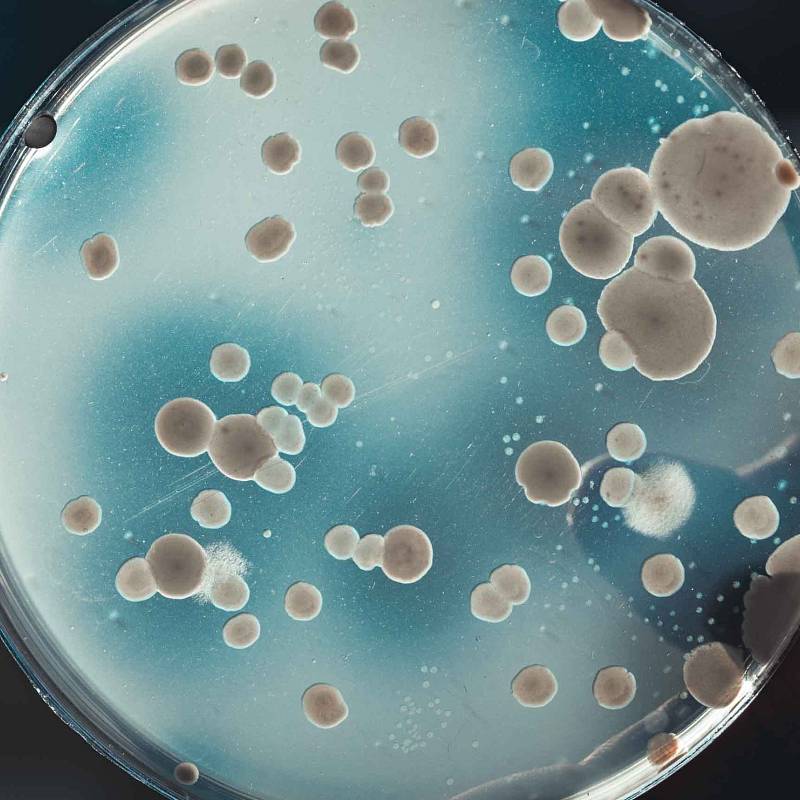
Petrischale mit wachsenden Bakterien- oder Pilzkulturen im Labor.

Verlässlich planen. Fundiert entscheiden.
Was 2002 als kleines Drei-Mann-Büro begann, ist heute ein breit aufgestelltes Ingenieurbüro mit rund 30 Mitarbeitenden – darunter erfahrene Natur- und Geowissenschaftler, Chemiker, Techniker, Laboranten und Fachkräfte aus dem administrativen Bereich. Bei gabex engineers bündeln wir über 23 Jahre Erfahrung mit einem modernen, interdisziplinären Ansatz.
Unser Ziel: Projekte ganzheitlich betreuen – von der Baugrunduntersuchung bis zur Raumluftanalyse, von der Sanierungsplanung bis zum Baugutachten. Dafür entnehmen wir Proben selbst und führen zahlreiche Prüfungen in unseren firmeneigenen Laboren durch – flexibel, unabhängig und schnell.
Mit Sitz in Bayreuth sind wir regional verwurzelt und betreuen Projekte in der gesamten Region und darüber hinaus – für kommunale Auftraggeber, Bauträger, Architekturbüros und Fachplaner, Industrieunternehmen sowie private Bauherrn.
Gabex engineers ist Ihr erfahrener Partner für komplexe Fragestellungen rund ums Bauen, Planen und Sanieren. Wir liefern keine Standardlösungen, sondern denken in Zusammenhängen – immer im Sinne unserer Kunden. Unser Anspruch ist es, nicht nur Ergebnisse zu liefern, sondern fundierte Entscheidungsgrundlagen mit klaren, umsetzbaren Handlungsempfehlungen.
Mit kurzen Wegen, eigener Laborinfrastruktur und einem vielseitigen Team bieten wir alles aus einer Hand – schnell, flexibel und fachlich auf dem neuesten Stand.
Das macht uns im Detail aus
Fachkompetenz für Bau, Umwelt & Sanierung
Unsere Leistungen für Ihr Bauvorhaben
Ganz gleich, ob es um die Bewertung des Baugrunds, die Sanierung belasteter Standorte, die Untersuchung von Baumängel oder um die Ausführung einer Raumluftanalyse geht – bei gabex engineers übernehmen wir nicht nur die Umsetzung von Analysen und Gutachten, zu unseren Ingenieurleistungen gehören auch die transparente Beratung im Hinblick auf Mängel und Schadstoffe, außerdem führen wir eine fundierte Wirtschaftlichkeitsanalyse für Ihr Bauvorhaben durch. Unsere interdisziplinär aufgestelltes Team aus unter anderem Baustoffprüfern und Sachgutachtern bringen langjährige Erfahrung in der Analyse und Instandsetzung von Bauwerken mit. Durch eigene Labore, gezielte Bauwerksdiagnosen und präzise Fachgutachten begleiten wir Ihr Projekt im Bauwesen effektiv, wirtschaftlich und mit dem nötigen Pragmatismus. Hier finden Sie einen Überblick über unsere zentralen Tätigkeitsfelder.

Karriere bei gabex engineers
Werden Sie Teil eines modernen Ingenieurbüros in der Region
Bei gabex engineers arbeiten Bauingenieure, Sachverständige, Laborprofis und viele weitere Fachkräfte Hand in Hand. Was uns verbindet: der Ansporn, gemeinsam Lösungen zu finden, die wirklich weiterhelfen – ob bei kleinen Bauprojekten oder komplexen Herausforderungen für öffentliche Auftraggeber.
Als vielseitiges Ingenieurbüro mit überregionalem Wirkungskreis sind wir in den Bereichen Geotechnik, Altlasten und Bauwerksuntersuchung zuhause. Wir verfügen über eigene Labore, moderne Ausstattung und kurze Wege – das macht unsere Arbeit effizient und praxisnah.
Wir wachsen und möchten unser Team gezielt verstärken. Deshalb sind wir laufend auf der Suche nach Menschen, die ihr Fachwissen einbringen und mit uns gemeinsam an Lösungen arbeiten möchten.
Sie sind interessiert? Werfen Sie einen Blick auf unsere aktuellen Stellenangebote – wir freuen uns, wenn Sie Teil unseres Teams werden!
Ihr Projekt - unser Service: Jetzt Kontakt aufnehmen
Sie planen ein Bauprojekt, benötigen ein Gutachten oder möchten mehr über unsere Leistungen erfahren? Wir freuen uns, von Ihnen zu hören! Egal, ob erste Projektidee oder konkrete Fragestellung – bei gabex engineers finden Sie ein offenes Ohr, fachliche Kompetenz und eine ehrliche Einschätzung.
Nutzen Sie unser Kontaktformular oder rufen Sie direkt an. Gemeinsam klären wir, wie wir Ihr Anliegen bestmöglich unterstützen können.
Besuchen Sie uns
Gottlieb-Keim-Straße 23
95448 Bayreuth
Oder kontaktieren Sie uns
Telefon: 0921 88060
E-Mail: info@gabex.de